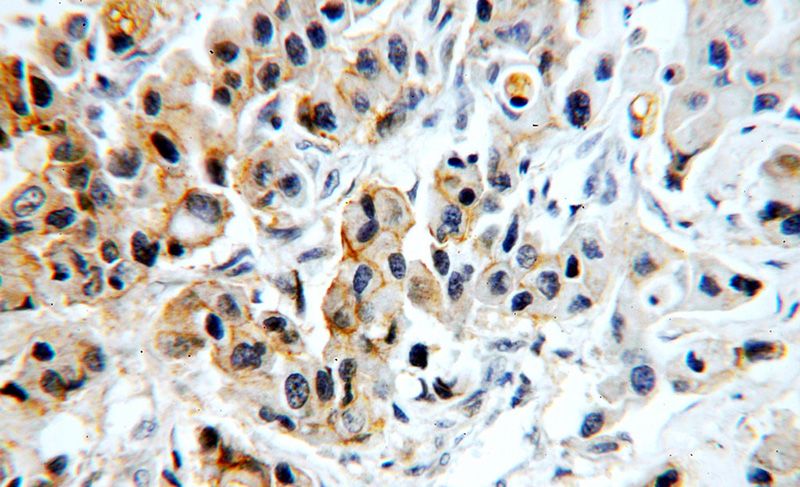
Immunohistochemical of paraffin-embedded human breast cancer using Catalog No:110346(EPCAM antibody) at dilution of 1:100 (under 40x lens)

-
Product Name
EPCAM antibody
- Documents
-
Description
EPCAM Rabbit Polyclonal antibody. Positive WB detected in A431 cells, COLO 320 cells, MCF7 cells, mouse colon tissue. Positive IHC detected in human breast cancer tissue, human colon cancer tissue, human colon tissue, human lung cancer tissue, human lung tissue, human stomach cancer tissue. Positive IF detected in A431 cells. Observed molecular weight by Western-blot: 40 kDa,45-50 kDa
-
Tested applications
ELISA, WB, IHC, IF
-
Species reactivity
Human, Mouse; other species not tested.
-
Alternative names
CD326 antibody; CO 17A antibody; CO17 1A antibody; EGP antibody; EGP 2 antibody; EGP314 antibody; EGP34 antibody; EGP40 antibody; Ep CAM antibody; EPCAM antibody; Epithelial glycoprotein antibody; Epithelial glycoprotein 314 antibody; ESA antibody; GA733 2 antibody; hEGP 2 antibody; hEGP314 antibody; KS 1/4 antigen antibody; KS1/4 antibody; KSA antibody; M1S2 antibody; M4S1 antibody; MIC18 antibody; MK 1 antibody; TACST 1 antibody; TACSTD1 antibody; TROP1 antibody
-
Isotype
Rabbit IgG
-
Preparation
This antibody was obtained by immunization of EPCAM recombinant protein (Accession Number: NM_002354). Purification method: Antigen affinity purified.
-
Clonality
Polyclonal
-
Formulation
PBS with 0.02% sodium azide and 50% glycerol pH 7.3.
-
Storage instructions
Store at -20℃. DO NOT ALIQUOT
-
Applications
Recommended Dilution:
WB: 1:200-1:2000
IHC: 1:20-1:200
IF: 1:20-1:200
-
Validations

A431 cells were subjected to SDS PAGE followed by western blot with Catalog No:110346(EPCAM antibody) at dilution of 1:200

Immunohistochemical of paraffin-embedded human breast cancer using Catalog No:110346(EPCAM antibody) at dilution of 1:100 (under 10x lens)
Immunohistochemical of paraffin-embedded human breast cancer using Catalog No:110346(EPCAM antibody) at dilution of 1:100 (under 40x lens)

Immunofluorescent analysis of A431 cells using Catalog No:110346(EPCAM Antibody) at dilution of 1:50 and Alexa Fluor 488-congugated AffiniPure Goat Anti-Rabbit IgG(H+L)
-
Background
Epithelial cell adhesion molecule (EpCAM, CD326) is a type I transmembrane glycoprotein that functions as a homophilic, epithelial-specific intercellular cell-adhesion molecule. In addition to cell adhesion, EpCAM is also involved in cellular signaling, cell migration, proliferation, and differentiation. EpCAM is highly expressed on most carcinomas and therefore of potential use as a diagnostic and prognostic marker for a variety of carcinomas, and has become a therapeutic target. (PMID: 20837599; 19249674; 21576002; 22647938)
-
References
- Sone M, Nishikawa Y, Nagahama Y. Recovery of mature hepatocytic phenotype following bile ductular transdifferentiation of rat hepatocytes in vitro. The American journal of pathology. 181(6):2094-104. 2012.
- Liang B, Peng P, Chen S. Characterization and proteomic analysis of ovarian cancer-derived exosomes. Journal of proteomics. 80:171-82. 2013.
- Xu C, Fillmore CM, Koyama S. Loss of Lkb1 and Pten leads to lung squamous cell carcinoma with elevated PD-L1 expression. Cancer cell. 25(5):590-604. 2014.
- Liu J, Cho SN, Akkanti B. ErbB2 Pathway Activation upon Smad4 Loss Promotes Lung Tumor Growth and Metastasis. Cell reports. 2015.
- Hiraga T, Ito S, Nakamura H. EpCAM expression in breast cancer cells is associated with enhanced bone metastasis formation. International journal of cancer. 138(7):1698-708. 2016.
- Enriquez VA, Cleys ER, Da Silveira JC, Spillman MA, Winger QA, Bouma GJ. High LIN28A Expressing Ovarian Cancer Cells Secrete Exosomes That Induce Invasion and Migration in HEK293 Cells. BioMed research international. 2015:701390. 2015.
Related Products / Services
Please note: All products are "FOR RESEARCH USE ONLY AND ARE NOT INTENDED FOR DIAGNOSTIC OR THERAPEUTIC USE"
